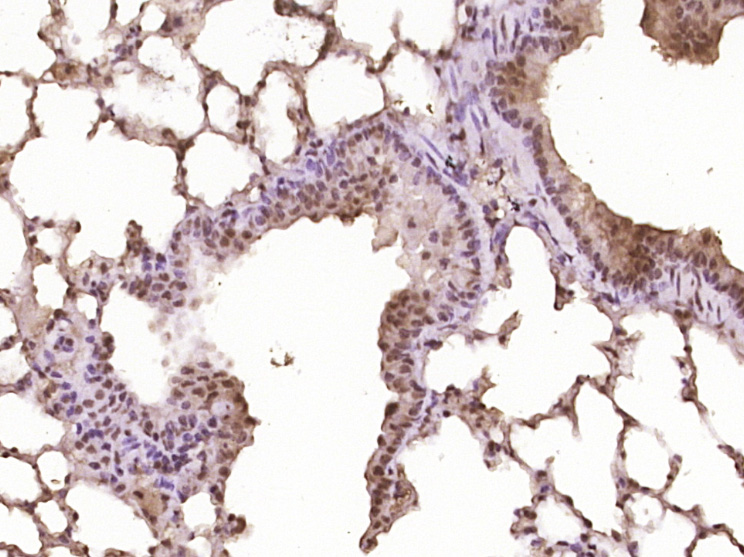
Activated Notch1 Rabbit pAb(bs

相关产品推荐更多 >
万千商家帮你免费找货
0 人在求购买到急需产品
- 详细信息
- 文献和实验
- 技术资料
- 应用范围:
产品信息以Bioss网站为准
- 规格:
50ul/100ul/200ul
| 规格: | 50ul | 产品价格: | ¥1180.0 |
|---|---|---|---|
| 规格: | 100ul | 产品价格: | ¥1980.0 |
| 规格: | 200ul | 产品价格: | ¥2800.0 |
| 产品编号 | bs-20252R |
| 英文名称 | Activated Notch1 Rabbit pAb |
| 中文名称 | 活化的Notch1蛋白抗体 |
| 英文别名 | Activated-notch1; Activated-notch 1; Activated notch 1; hN1; Neurogenic locus Notch homolog protein 1; activated Notch 1; activated Notch-1; Notch homolog 1 translocation associated(Drosophila); NOTCH1; TAN1; Translocation-associated Notch protein TAN-1; NOTC1_HUMAN. |
| 产品应用 | WB=1:500-2000, IHC-P=1:100-500, IHC-F=1:100-500, IF=1:100-500 Not yet tested in other applications. |
| 交叉反应 | Mouse (Human, Rat, Dog, Pig, Cow, Rabbit, GuineaPig) |
| 抗体来源 | Rabbit |
| 免疫原 | KLH conjugated synthetic peptide derived from human N-terminal sequence of the cleaved Notch1 intracellular domain |
| 亚型 | IgG |
| 性状 | Liquid |
| 纯化方法 | affinity purified by Protein A |
| 克隆类型 | Polyclonal |
| 理论分子量 | 271 kDa |
| 浓度 | 1mg/ml |
| 储存液 | 0.01M TBS (pH7.4) with 1% BSA, 0.02% Proclin300 and 50% Glycerol. |
| 研究领域 | Cardiovascular > Heart > Cardiogenesis > Transcription factors/regulators Developmental Biology > Embryogenesis > Somatogenesis Epigenetics and Nuclear Signaling > Transcription > Other factors Neuroscience > Neurology process > Notch Pathway Stem Cells > Hematopoietic Progenitors > Surface Molecules Stem Cells > Signaling Pathways > Notch > Surface Molecules |
| 亚基 | Heterodimer of a C-terminal fragment N(TM) and an N-terminal fragment N(EC) which are probably linked by disulfide bonds. Interacts with DNER, DTX1, DTX2 and RBPJ/RBPSUH. Also interacts with MAML1, MAML2 and MAML3 which act as transcriptional coactivators for NOTCH1. The activated membrane-bound form interacts with AAK1 which promotes NOTCH1 stabilization. Forms a trimeric complex with FBXW7 and SGK1. Interacts with HIF1AN. HIF1AN negatively regulates the function of notch intracellular domain (NICD), accelerating myogenic differentiation. |
| 亚细胞定位 | Cell membrane and Nucleus. Following proteolytical processing NICD is translocated to the nucleus. |
| 组织特异性 | In fetal tissues most abundant in spleen, brain stem and lung. Also present in most adult tissues where it is found mainly in lymphoid tissues. |
| 翻译后修饰 | Synthesized in the endoplasmic reticulum as an inactive form which is proteolytically cleaved by a furin-like convertase in the trans-Golgi network before it reaches the plasma membrane to yield an active, ligand-accessible form. Cleavage results in a C-terminal fragment N(TM) and a N-terminal fragment N(EC). Following ligand binding, it is cleaved by TNF-alpha converting enzyme (TACE) to yield a membrane-associated intermediate fragment called notch extracellular truncation (NEXT). This fragment is then cleaved by presenilin dependent gamma-secretase to release a notch-derived peptide containing the intracellular domain (NICD) from the membrane. Phosphorylated. O-glycosylated on the EGF-like domains. Contains both O-linked fucose and O-linked glucose. Ubiquitinated; undergoes 'Lys-29'-linked polyubiquitination catalyzed by ITCH. |
| 相似性 | Belongs to the NOTCH family. Contains 5 ANK repeats. Contains 36 EGF-like domains. Contains 3 LNR (Lin/Notch) repeats. |
| 功能 | Functions as a receptor for membrane-bound ligands Jagged1, Jagged2 and Delta1 to regulate cell-fate determination. Upon ligand activation through the released notch intracellular domain (NICD) it forms a transcriptional activator complex with RBPJ/RBPSUH and activates genes of the enhancer of split locus. Affects the implementation of differentiation, proliferation and apoptotic programs. May be important for normal lymphocyte function. In altered form, may contribute to transformation or progression in some T-cell neoplasms. Involved in the maturation of both CD4+ and CD8+ cells in the thymus. May be important for follicular differentiation and possibly cell fate selection within the follicle. During cerebellar development, may function as a receptor for neuronal DNER and may be involved in the differentiation of Bergmann glia. |
| 保存条件 | Shipped at 4℃. Store at -20℃ for one year. Avoid repeated freeze/thaw cycles. |
| 注意事项 | This product as supplied is intended for research use only, not for use in human, therapeutic or diagnostic applications. |
| 背景资料 | This gene encodes a member of the Notch family. Members of this Type 1 transmembrane protein family share structural characteristics including an extracellular domain consisting of multiple epidermal growth factor-like (EGF) repeats, and an intracellular domain consisting of multiple, different domain types. Notch family members play a role in a variety of developmental processes by controlling cell fate decisions. The Notch signaling network is an evolutionarily conserved intercellular signaling pathway which regulates interactions between physically adjacent cells. In Drosophilia, notch interaction with its cell-bound ligands (delta, serrate) establishes an intercellular signaling pathway that plays a key role in development. Homologues of the notch-ligands have also been identified in human, but precise interactions between these ligands and the human notch homologues remain to be determined. This protein is cleaved in the trans-Golgi network, and presented on the cell surface as a heterodimer. This protein functions as a receptor for membrane bound ligands, and may play multiple roles during development. [provided by RefSeq, Jul 2008]. |
| 应用 | 推荐稀释比例 |
| {WB} | {1:500-2000} |
| {IHC-P} | {1:100-500} |
| {IHC-F} | {1:100-500} |
| {IF} | {1:100-500} |

Primary: Anti-Activated Notch1(bs-20252R)at 1/300 dilution
Secondary: IRDye800CW Goat Anti-RabbitIgG at 1/20000 dilution
Predicted band size: 86kD
Observed band size: 107kD

风险提示:丁香通仅作为第三方平台,为商家信息发布提供平台空间。用户咨询产品时请注意保护个人信息及财产安全,合理判断,谨慎选购商品,商家和用户对交易行为负责。对于医疗器械类产品,请先查证核实企业经营资质和医疗器械产品注册证情况。
文献和实验[IF={{ 3.8 }}] {Zhan Ping. et al. The activation of the Notch signaling pathway by UBE2C promotes the proliferation and metastasis of hepatocellular carcinoma. SCI REP-UK. 2024 Oct;14(1):1-15} {IHC} {Human}
[IF={{ 2.9 }}] {Xiao-yue Guan. et al. Blocking Gremlin1 inhibits M1 macrophage polarization through Notch1/Hes1 signaling pathway in apical periodontitis. IMMUNOPHARM IMMUNOT. 2024 八月 27} {IHC} {Rat}
技术资料暂无技术资料 索取技术资料







